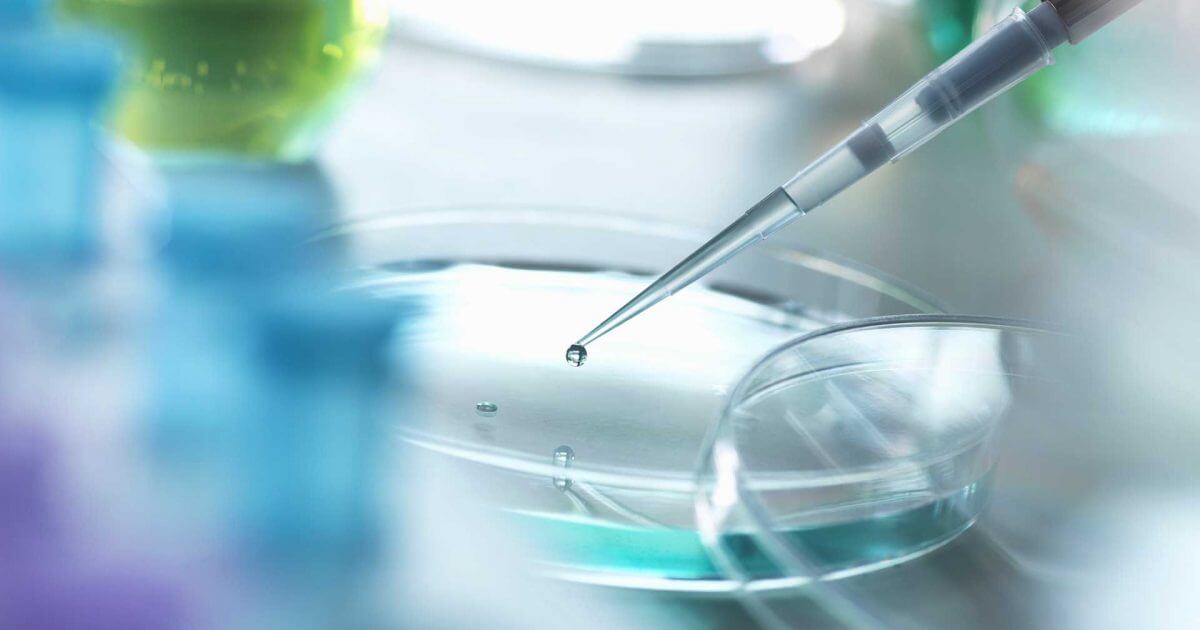
البدء من جديد: إعادة برمجة الخلايا في الطب التجديدي | قصص | موقع مجموعة أجينوموتو العالمية - تناول الطعام بشكل جيد، عش بشكل جيد.

مستقبل الطب التجديدي: الطب الشخصي والتكنولوجيا الحيوية في خدمة الصحة العامة
تعيش ميدان الطب في عصر تحولات ملحوظة، حيث تندمج التكنولوجيا والابتكارات الحيوية لتحديد مستقبل الرعاية الصحية. يتسارع التطور في مجال الطب التجديدي، ويتوقع أن يلعب الطب الشخصي والتكنولوجيا الحيوية دورًا حيويًا في تحسين الخدمات الطبية وتكاملها بشكل أفضل مع احتياجات المرضى والمجتمع بشكل عام.
الطب الشخصي (Precision Medicine):
تعد الطب الشخصي من أهم الابتكارات في مجال الرعاية الصحية، حيث يتم تخصيص العلاج بشكل دقيق وفعّال وفقًا للتفاوتات الجينية والتاريخ الطبي لكل فرد. يمكن لتحليل الجينوم الشخصي أن يوفر فهمًا أعمق حول كيفية استجابة الفرد للعلاجات، مما يسهم في تخصيص علاجات فعّالة وتقليل الآثار الجانبية.
التكنولوجيا الحيوية (Biotechnology):
تأخذ التكنولوجيا الحيوية دورًا متزايد الأهمية في تطوير علاجات جديدة وتحسين تشخيص الأمراض. يعتمد هذا النهج على استخدام الخلايا والبروتينات والأحماض النووية لتطوير علاجات مستهدفة لمجموعة واسعة من الأمراض. مثلًا، يتم استخدام تقنيات التحرير الجيني CRISPR-Cas9 في تعديل الجينات المسؤولة عن الأمراض الوراثية.
الذكاء الاصطناعي (AI) في تحليل البيانات الطبية:
تلعب الذكاء الاصطناعي دورًا حيويًا في تحليل البيانات الضخمة المتعلقة بالصحة. يمكن للأنظمة الذكية تحديد الاتجاهات والتنبؤ بتطور الأمراض، مما يساعد في اتخاذ قرارات طبية أفضل وتخصيص الموارد بشكل أكثر فعالية.
الطب العابر للحدود (Telemedicine):
تسهم التكنولوجيا في تطوير الرعاية الصحية عبر الإنترنت، مما يتيح للمرضى التواصل مع الأطباء واستشاريين الصحة عبر الشاشات. يسهم هذا التطور في توسيع الوصول إلى الرعاية الصحية وتحسين التواصل بين الأطباء والمرضى.
الطب البائيونيكي (Bionics):
تسعى التقنيات البائيونية إلى دمج أجهزة إلكترونية متطورة مع الأعضاء البشرية لتحسين وظائف الجسم. مثلًا، يتم تطوير أطراف صناعية ذكية قابلة للتحكم بواسطة العقل، مما يساهم في تحسين حياة الأشخاص الذين فقدوا أطرافهم.
مستقبل الطب التجديدي يتسم بالتنوع والتطور السريع. من خلال تكامل الطب الشخصي والتكنولوجيا الحيوية مع الذكاء الاصطناعي والطب البائيونيكي، يشهد العالم الطبي تحولات هائلة تعد بتحسين جودة الرعاية الصحية وتمكين المرضى بشكل لم يحدث من قبل. تبقى التحديات الأخلاقية والأمانية جزءًا مهمًا من هذا التطور، ومع ذلك، يبدو أن مستقبل الطب يعد بفترة مثيرة من الابتكار والتحسين المستمر.